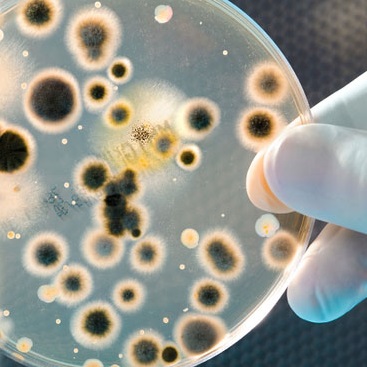

-

-
 计算机系统验证与 21CFR Part11之间的关系 MORE+
计算机系统验证与 21CFR Part11之间的关系 MORE+时间:2015-12
作者:点风科技
1997年,美国FDA发布了21 CFR Part11,该法规主要阐述了关于电子记录和电子记录使用方面的规范和所需要的控...
-

-
 GMP新附录计算机系统验证过程中用户的作用 MORE+
GMP新附录计算机系统验证过程中用户的作用 MORE+时间:2015-11
作者:点风科技
新版GMP附录的发布对应用于药品生产相关的计算机系统的验证有了明确的要求,虽然迟到了很多年,但对提高行...
-
 Excel在GxP环境下的合规验证——基本概念 MORE+
Excel在GxP环境下的合规验证——基本概念 MORE+时间:2015-11
作者:点风科技
对于类似Excel电子表格类的应用程序,在合规领域GxP(GLP、GMP、GCP)使用时,必须是受控的和经过验证确认...
-
 Excel在合规环境中使用所面临的问题 MORE+
Excel在合规环境中使用所面临的问题 MORE+时间:2015-11
作者:点风科技
电子表格软件是使用最广泛,最受各种企业青睐的软件之一。电子表格软件中的杰出者Excel以其易用性和灵活性...
-
-
 构建符合21 CFR Part11的安全控制机制 MORE+
构建符合21 CFR Part11的安全控制机制 MORE+时间:2015-11
作者:点风科技
联邦法规21章第11款即CFR Part11主要规定内容涉及电子记录和电子签名,在此标准之下FDA将认为电子记录、电...
-

-

